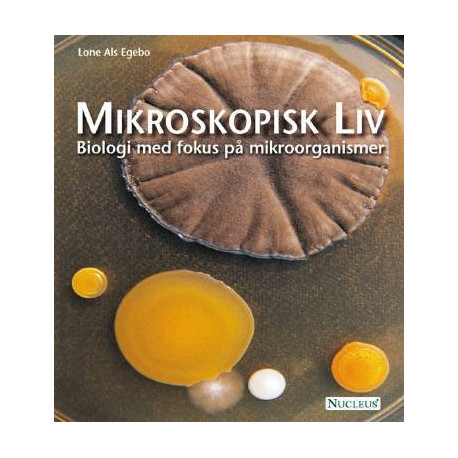

Kurv
Vare
varer
(tom)
Ingen varer
Fastlægges senere
Forsendelse
0,- kr
I alt
Mikroskopisk Liv: Biologi med fokus på mikroorganismer
(Bog, Hæftet, Dansk)
Nedsat pris!

Forlag:
Nucleus
- Type: Bog
- Format: Hæftet
-
Sprog:
Dansk

- ISBN-13: 9788790363277
- Se flere detaljer ▼
Bemærk: Kan leveres før jul.
Beskrivelse
Bakterier, arkæer, alger, svampe og protozoer - det vrimler med mikroskopisk liv omkring os. De usynlige mikroorganismer er uundværlige aktører på godt og ondt fx i maden, i kroppen og i økosystemer, og vi udnytter dem både i naturbaserede og industrielle produktioner.
Mikroskopisk liv er skrevet til biologiundervisningen på alle de gymnasiale uddannelsers B- og A-niveau og kan oså anvendes i læreruddannelsens linjefagsundervisning i biologi og natur-teknik.
Måske kunne nedenstående have interesse
Har du brug for en notesbog?
Se vores store udvalg af notesbøger i høj kvalitet. Vi har bl.a. notesbøger fra mærker som Moleskine og Paperblanks.
Læsernes anmeldelser (0)
Alle detaljer
| Forlag | Nucleus |
| Forfatter | Lone Als Egebo |
| Type | Bog |
| Format | Hæftet |
| Sprog | Dansk |
| Udgave | 1. (30-09-2004) |
| Oplag | 4. (03-01-2006) |
| Første udgivelsesår | 2004 |
| Tegnet af | Erik Hjørne |
| Fagredaktør | Steen Ussing, Birthe Møller Nielsen |
| Originalsprog | Dansk |
| Sideantal | 112 |
| Indbinding | Hæftet |
| ISBN-13 / EAN-13 | 9788790363277 |

